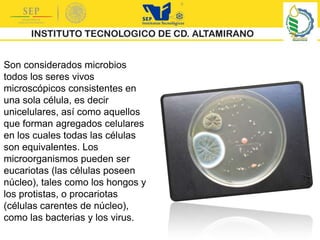
Son considerados microbios
todos los seres vivos
microscópicos consistentes en
una sola célula, es decir
unicelulares, así como aquellos
que forman agregados celulares
en los cuales todas las células
son equivalentes. Los
microorganismos pueden ser
eucariotas (las células poseen
núcleo), tales como los hongos y
los protistas, o procariotas
(células carentes de núcleo),
como las bacterias y los virus.

La microbiología es la ciencia que estudia los microorganismos. Ha estado presente desde antes de conocer su existencia, ya que procesos como la fermentación son provocados por microbios. A lo largo de la historia, científicos como van Leeuwenhoek, Pasteur y Koch descubrieron y estudiaron bacterias y determinaron que causan enfermedades, sentando las bases de esta disciplina. Aunque se han hecho grandes avances, todavía queda mucho por descubrir sobre los microorganismos.